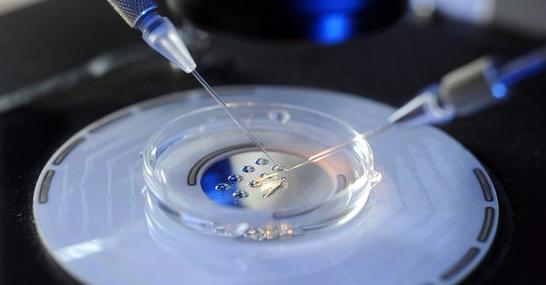
女性一辈子可以捐几次卵子,捐卵子3次

医生,我女朋友得的是什么病?一个男生坐在医生办公室里,迫不及待地问。
医生沉思了一会,说出了一个医学术语,卵巢过度刺激综合征。
卵巢过度刺激综合征?男生又重复了一遍,脸上充满困惑。
的确,很多人都未曾听说过这个医学术语,它是体外受孕辅助生育的主要并发症之一。 多见于促性腺激素(HMG/HMG hCG等)治疗期间,表现为恶心、呕吐、腹部不适、体重增加、卵巢增大、胸腹腔积液、少尿、水电解质平衡紊乱、肾衰、血栓形成等,严重的可危及生命。
简单点来说,为了刺激排卵,往往会使用一些促排卵药物,所以卵巢过度刺激综合征,其实也是促排卵药物导致的严重副作用。
医生试图通过通俗易懂的方式来解释,男生听的是目瞪口呆,过了一会,他又立刻恍然大悟,然后对医生说,我明白了。

真相究竟是什么?
患者是一名21岁的高校大学生,为何会突然罹患卵巢过度刺激综合征?男友百思不得其解,真相躲在暗无天日的秘密角落里,等待着人们的开启。
卵巢过度刺激综合征,这是一种极为严重的疾病,它可能导致三种极为严重的并发症,①多囊卵巢综合征(PCOS),其发生机制未明,可能主要与血管内皮生长因素(VEGF)的过度表达、前列腺素合成过多、炎性因子及血管紧张素-2(AT-2)释放等因素有关。②血栓栓塞性病变,尤其对已存在高凝状态者来说。辅助生育过度刺激卵巢后可发生严重的血栓栓塞性病变。③多胎妊娠和异位妊娠,主要是多个卵子同时成熟,同时受孕所致。临床上使用排卵诱导剂,如人绒毛膜促性腺激素(HCG)、人绝经后促性腺激素(HMG)及氯米芬时,卵巢被过度刺激而引起的一系列临床表现。严重者可危及生命。
万幸的是,通过积极的抢救,这个女生终于转危为安,不幸的是,医生说,会终身不孕。
不过这与生命相比,的确算不了什么,因为卵巢过度刺激综合征有可能致命,也就是说,能保命已经实属不幸。
听完医生的告知,女生顿时失声痛哭,一时的冲动却换来了终身的遗憾,这是报应还是?
为了赚钱,瞒着家人,瞒着男友,一年进行了两次捐卵,以为年轻,身体能扛住,却不知道,自食恶果,为此付出了沉重的代价。

医生说,女生捐卵可不像男生捐精子,捐献卵子与捐献精子有很大的不同,男性捐献精子对身体几乎是毫无损伤,但卵子捐献却要复杂得多。捐卵子需要使用促排卵药物让女性能一次排出多个卵子,而后取出这些成熟的卵细胞,在体外受精,之后通过药物让女性生殖系统进入怀孕的状态,最终将受精卵植入到子宫腔内继续发育的技术。卵子捐献者会参与到的环节是超排卵与取卵,但就是这2个环节,会给卵子捐献者带来很大的健康隐患与风险。

首先,促排卵药物会对身体造成影响,特别是导致卵巢过度刺激综合征。
其次,取卵手术也会对身体造成伤害。即便一些正规医疗机构都不能避免这些风险,更不用说那些从事内幕交易的违法中介了,不知道其中利弊的大学生,一旦上当,在金钱的驱使下,很容易走上不归之路。
得知真相的男友怒不可止,骂了女友一句混蛋,然后愤怒离开。